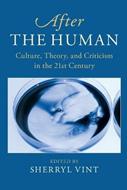

L’articolo è stato aggiunto alla lista dei desideri
IBS.it, l'altro eCommerce
After the Human: Culture, Theory and Criticism in the 21st Century
Cliccando su “Conferma” dichiari che il contenuto da te inserito è conforme alle Condizioni Generali d’Uso del Sito ed alle Linee Guida sui Contenuti Vietati. Puoi rileggere e modificare e successivamente confermare il tuo contenuto. Tra poche ore lo troverai online (in caso contrario verifica la conformità del contenuto alle policy del Sito).
Grazie per la tua recensione!
Tra poche ore la vedrai online (in caso contrario verifica la conformità del testo alle nostre linee guida). Dopo la pubblicazione per te +4 punti
Altre offerte vendute e spedite dai nostri venditori

Tutti i formati ed edizioni
Promo attive (1)
After the Human provides a comprehensive overview of how a range of philosophical, ethical, and political ideas under the framework of posthumanism have transformed humanities scholarship today. Bringing together a range of interdisciplinary scholars and perspectives, it puts into dialogue the major influences from philosophy, literary study, anthropology, and science studies that set the stage for a range of new questions to be asked about the relationship of the human to other life. The book's central argument is that posthumanism's challenge to and disruption of traditional humanist knowledge is so significant as to presage a sea-change from the humanities into the posthumanities. After the Human documents the emergence of posthumanist ideas in the fractures within traditional disciplines, examines the new objects of analysis that thus came into prominence, and theorizes new interdisciplinary methods of study that followed.
L'articolo è stato aggiunto al carrello
Le schede prodotto sono aggiornate in conformità al Regolamento UE 988/2023. Laddove ci fossero taluni dati non disponibili per ragioni indipendenti da IBS, vi informiamo che stiamo compiendo ogni ragionevole sforzo per inserirli. Vi invitiamo a controllare periodicamente il sito www.ibs.it per eventuali novità e aggiornamenti.
Per le vendite di prodotti da terze parti, ciascun venditore si assume la piena e diretta responsabilità per la commercializzazione del prodotto e per la sua conformità al Regolamento UE 988/2023, nonché alle normative nazionali ed europee vigenti.
Per informazioni sulla sicurezza dei prodotti, contattare productsafetyibs@feltrinelli.it
L’articolo è stato aggiunto alla lista dei desideri

